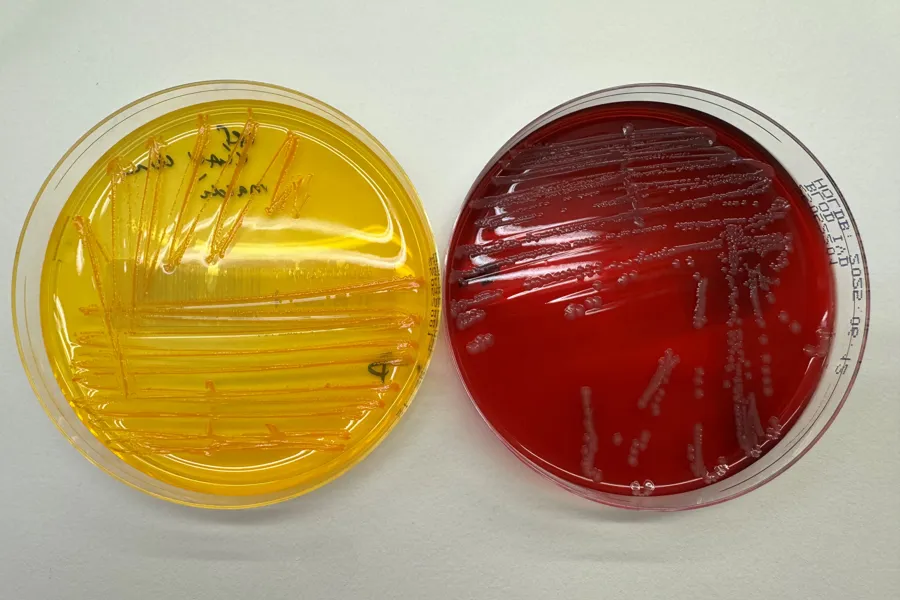
Noen få forskjellige fargede mynter

Test for resistente mikrober før innleggelse i sommermånedene
Sommeren nærmer seg, og med økt reiseaktivitet og pasientflyt minner vi om viktigheten av å teste aktuelle pasienter for resistente mikrober (MRSA, VRE, ESBL) før innleggelse i sykehus. Dette bidrar til å hindre smittespredning og sikre trygg pasientbehandling.
Publisert 06.06.2025
Testingen bør gjennomføres i forkant av innleggelse, og gjelder pasienter i definerte risikogrupper.
Informasjon om hvilke pasienter som skal testes, hvilke prøver som skal tas og hvordan dette gjøres, finner du på nettsiden: Testing av mikrober før innleggelse i sykehus - Kompetansebroen
Kontaktinformasjon ved spørsmål
- Fellesmail.smittevern@ahus.no
- 67 96 43 99
Retningslinjene er basert på anbefalinger fra Folkehelseinstituttet (FHI), med lokale tilpasninger for Ahus.